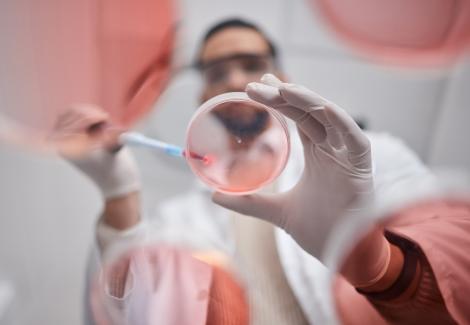
Tipul de cercetare care ar putea distruge toată viața de pe Pământ. De ce e atât de periculoasă

Articole despre cercetare

Baza subacvatică unde oamenii pot locui săptămâni întregi. La ce adâncime record ar putea fi construită
Baza subacvatică unde oamenii pot locui săptămâni întregi ar putea deveni realitate în curând și le-ar putea oferi cercetătorilor un nou laborator de studiu.
Luni, 03.11.2025, 14:16
Tipul de cercetare care ar putea distruge toată viața de pe Pământ. De ce e atât de periculoasă
Experții cer ca tipul de cercetare care ar putea distruge toată viața de pe Pământ să fie întrerupt, pentru binele planetei.
Miercuri, 24.09.2025, 17:23
Cercetările premiate cu Ig Nobel în 2025. Care au fost cele mai bizare studii științifice din acest an
Au fost dezvăluite cercetările premiate cu Ig Nobel în 2025, premii care sunt acordate celor mai bizare studii științifice din acest an.
Vineri, 19.09.2025, 15:35
Aduc sau nu banii fericirea? Ce spun oamenii de știință despre cea mai mare dilemă a societății
Zicala: „Banii nu aduc fericirea!” este de multe ori contrazisă de situațiile de viață. Cu toate acestea oamenii de știință au demonstrat contrariul.
Sambata, 10.02.2024, 14:22
De ce românii trăiesc mai prost și mai puțin decât ceilalți europeni. Aceștia au o speranță de viață mai mică
Prof. dr. Vasile Ghețău, expert în demografie afirmă că speranța de viață la naștere a fost dintotdeauna mică la români și a rămas așa, ba mai mult, comparativ cu alți europeni, românii sunt la coada clasamentului.
Marti, 19.09.2023, 15:03
Creatura cu nume de fruct și înfățișare de extraterestru descoperită în apele adânci ale lumii. A stârnit uimire. Ce este
Creatura a fost descoperită în apele din apropierea Antarcticii. Cei care au descoperit-o au fost surprinși de apariția inedită.
Sambata, 02.09.2023, 13:25
Românii sunt în topul consumatorilor de alcool. Ce loc ocupăm și câtă băutură consumăm, în medie
Recent, s-a realizat un studiu în 189 de țări privind consumul mediu de alcool. În urma acestuia s-a arătat că România este în topul acestor țări; ocupă locul 14.
Vineri, 25.08.2023, 17:48
Cel mai bătrân om modern din lume a fost „readus la viață”. Cum arăta fața femeii care a trăit lângă România, acum mii de ani
Craniul unei femei care a trăit în urmă 45.000 de ani a fost descoperit în apropiera tării noastre. Folosind măsurători și realitatea vituală, cercetătorii au reușit să recreeze chipul femeii, iar rezultatul este surprinzător.
Vineri, 04.08.2023, 14:47
UE alocă 10 de milioane de euro pentru activităţi de cercetare cu privire la coronavirus/ Cererile de finanţare trebuie depuse până în 12 februarie
Comisia Europeană a anunţat că va aloca 10 milioane de euro din programul său de cercetare şi inovare, Orizont 2020, pentru a sprijini cercetarea bolii cauzate de noul coronavirus. Comisia a lansat o cerere urgentă de exprimare a interesului faţă de proiecte de cercetare care să contribuie la o mai bună înţelegere a focarului de coronavirus şi la o mai bună gestionare clinică a pacienţilor infectaţi cu virusul, precum şi la îmbunătăţirea pregătirii şi a răspunsului în materie de sănătate publică.
Vineri, 31.01.2020, 17:01
Descoperire uluitoare! Au fost găsite crăpături în textura Universului, formate la puţin timp după Big Bang
Ar putea exista crăpături în textura spaţiu-timp din care este format Universul, fisuri rămase din perioada de imediat după Big Bang, însă telescoapele actuale nu le pot detecta, conform unui nou studiu publicat în arXiv.org, semnat de cercetătorul de origine română Răzvan Ciucă, de la Marianopolis College, din Westmount, Quebec, şi de Oscar Hernández de la Universitatea McGill din Montreal, Canada.
Joi, 28.11.2019, 20:39
O legumă adusă din America de Sud, alternativă la nelipsiţii cartofi. Cum se găteşte yaconul şi ce proprietăţi are
Vremea care trece de la o extremă la alta afectează tot mai mult agricultura românească. Însă cercetătorii vin cu alternative. Dau deja roade culturile experimentale cu plante mai puţin cunoscute. În loc de cartofi, am putea mânca Yacon. Iar...
Miercuri, 30.10.2019, 19:38
Tu știai? Apa nu este cea mai hidratantă băutură. Cât de hidratante sunt cafeaua, berea sau laptele
Potrivit unui studiu al Universității din St. Andrews din Scoția, care a comparat răspunsurile oamenilor cu privirea la cele mai hidratante băuturi, s-a descoperit faptul că există băuturi mai hidratante sau la fel de hidratante ca apa.
Joi, 26.09.2019, 09:50
Explozie cu risc mare de contaminare în Rusia, într-un centru de cercetare al viruşilor
Incident alarmant în Rusia. Un centru de cercetare al viruşilor a fost afectat de o explozie puternică urmată de un incendiu.Un recipient cu gaz a sărit în aer într-un laborator, dar autorităţile dau asigurări că pericolul de contaminare...
Marti, 17.09.2019, 19:45
Studiu: Cadavrele se mișcă după un an de la deces. Care sunt cauzele
O echipă de oameni de ştiinţă din „prima fermă de corpuri” din Australia a înregistrat, cu ajutorul camerelor de filmare secvenţială montate într-un centru de cercetare, mişcările cadavrelor în timpul procesului de descompunere.
Luni, 16.09.2019, 12:56
J.K. Rowling a donat 15,3 milioane de lire sterline unui centru din Edinburgh care sprijină cercetarea sclerozei multiple
J.K. Rowling a donat 15,3 milioane de lire sterline cu scopul de a sprijini cercetările afecţiunilor neurologice la centrul care poartă numele mamei scriitoarei, informează BBC.
Joi, 12.09.2019, 13:00
Există monstrul din Loch Ness? Ce a descoperit un grup de cercetători
Monstrul din Loch Ness, celebra legendă din Scoția, ar putea exista. A fost considerată o farsă, cu toate că există și o fotografie care dovedește că monstrul trăiește în apele lacului. Oamenii de știință au venit cu o nouă teorie, ar putea fi o anghilă uriașă.
Vineri, 06.09.2019, 09:10
Un șarpe cu două capete a fost găsit într-o pădure. Are patru ochi și două limbi strălucitoare VIDEO
Un șarpe cu două capete a fost descoperit într-o pădure din New Jersey, America. Reptila are patru ochi și două limbi strălucitoare care funcționează independent unul de celălalt.
Vineri, 06.09.2019, 08:39
Descoperire revoluționară! Studiul care dovedește că NU ne sunt ascultate telefoanele
O companie de securitate mobilă a efectuat o investigație de cercetare pentru a descoperi dacă teoria conform căreia giganții tehnologici ascultă conversațiile este adevărată.
Joi, 05.09.2019, 13:50
Legume ciudate în serele din Buzău! Ce vor găsi românii în piețe, în curând
În serele Staţiunii de Cercetare din Buzău, răsadurile se întind cât vezi cu ochii. Aici poți vedea cele mai bizare legume din toată țara! Ce anume le face deosebite?
Miercuri, 07.08.2019, 16:43
Legume ciudat, obținute în serele din Buzău
În serele Staţiunii de Cercetare din Buzău, răsadurile de legume se întind cât vezi cu ochii. Poposim aici să culegem tot ce trebuie pentru prepararea unei salate, pe cât de delicioase, pe atât de inedite. Tomatele, vedetele verii, vor fi în...
Miercuri, 07.08.2019, 12:49
Descoperire uluitoare! Elixirul tinereții este o proteină. Cercetătorii anunță că aceasta ar putea ajuta și la tratarea artritei
O echipă de cercetători spanioli a descoperit noi funcţii ale unei proteine care ar putea ajuta la evitarea deteriorării celulare şi la întârzierea îmbătrânirii, o descoperire ce poate fi cheie în alinarea unor boli precum artrita, relatează EFE.
Joi, 01.08.2019, 15:35
România, lovită de un nou cutremur! Un seism a avut loc în Buzău
România s-a cutremurat în noaptea de joi spre vineri, când un seism cu magnitudinea de 2,7 pe scara Richter s-a produs, în noaptea de joi spre vineri, la ora 1.37, în judeţul Buzău, informează Institutul Naţional de Cercetare-Dezvoltare pentru Fizica Pământului.
Vineri, 26.07.2019, 07:42
Leo de la Strehaia a fost reţinut. Acesta a fost audiat în dosarul în care este cercetat fiul său. VIDEO
Leo de la Strehaia a fost reţinut pentru 24 de ore, joi seară, după ce a fost audiat timp de mai multe ore de poliţiştii din Bucureşti, în dosarul în care şi fiul său este cercetat pentru înşelăciune cu aparate de aer condiţionat.
Joi, 18.07.2019, 22:17
Leo de la Strehaia audiat în dosarul fiului său. Acesta este cercetat pentru înșelăciune cu aparate de aer condiționat
Leo de la Strehaia este audiat, joi, de poliţiştii din Bucureşti în dosarul în care fiul său este cercetat pentru înşelăciune cu aparate de aer condiţionat. Prejudiciul este estimat la 300.000 de lei, iar poliţiştii suspectează că şi Leo de la Strehaia ar fi implicat.
Joi, 18.07.2019, 16:56
Relansarea Institutului Cantacuzino: Peste 100 de posturi scoase la consurs, investiții de 40 de milioane de lei pentru noi echipamente
Ministerul Apărării Naționale a anunțat, vineri, demararea procedurilor pentru ocuparea prin concurs a peste 100 de posturi de cercetători, medici, biologi, biochimiști, farmaciști și ingineri în cadrul Institutului Național de Cercetare-Dezvoltare Medico-Militară „Cantacuzino”, anunță Agerpres.
Vineri, 24.05.2019, 17:52
Momente dramatice la cercetarea unui accident rutier. Un martor a trăit un şoc emoţional puternic, iar poliţiştii au fost nevoiţi să îl încătuşeze
Momente dramatice, surprinse dimineaţă lângă Bucureşti, la un teribil accident rutier. Un om a murit, şapte au fost răniţi, iar poliţiştii au fost nevoiţi să încătuşeze un bărbat care a suferit un puternic şoc emoţional. Omul,...
Sambata, 06.04.2019, 19:09
Avocata falsă a lui Matteo Politi și trei funcționare de la DSP, reținute, în urma perchezițiilor făcute în dosarul falsului medic
Polițiștii de la Direcția de Investigare a Criminalității Economice au descins, în această dimineață, în două apartamente și în două sedii ale Direcției de Sănătate Publică a Municipiului București, fiind vizați trei funcționari publici care ar fi falsificat documente și ar fi eliberat cod de parafă, în baza unui consilier juridic. Este, de asemenea, cercetat și un consilier juridic.
Luni, 25.03.2019, 22:20
O angajată de la Serviciul de permise auto și înmatriculări, prinsă în timp ce lua mită! Femeia e cercetată pentru 13 infracțiuni
O femeie, angajată a Serviciului Public Comunitar Regim Permise de Conducere și Înmatriculare a Vehiculelor Hunedoara, a fost reținută de ofițerii DGA, după ce a fost prinsă în flagrant, în timp ce primea mită.
Miercuri, 13.03.2019, 10:19
Românii sunt în căutarea mereleor de aur. După ce cidrul a devenit şi la noi o modă
Din cele 20 de soiuri de mere cultivate în România lipsesc cele din care se face cidru. Este un neajuns pe care mai marii din Agricultură încearcă să-l remedieze. Un soi olandez va fi aclimatizat într-o staţiune de cercetare din Argeş, în...
Sambata, 02.03.2019, 19:40
S-a dovedit științific că un pahar de vin roșu echivalează cu 1 oră de sport. Care este substanța minune pe care o conține
Un studiu recent realizat la Universitatea Alberta din Canada, arată că un pahar de vin roșu este la fel de benefic pentru sănătate ca și o oră petrecută în sala de forță.
Sambata, 09.02.2019, 23:55
Scad salariile pentru acești români! Cine riscă să primească cu 10% mai puțini bani
Salariile ar putea scădea cu zece procente în acest an pentru o categorie de angajați din România, dacă conducerea țării nu va decide să împiedice acest lucru.
Sambata, 12.01.2019, 09:56
Tu știai? Legătura dintre alimentație și depresie este una neașteptată
Un studio neobișnuit făcut de cercetătorii australieni de la James Cook University arată că la persoanele din Strâmtoarea Torres cantitatea de peste și hrană procesată consumate sunt asociate cu depresia.
Miercuri, 17.10.2018, 15:41
Lovitură dură pentru zeci de mii de români! Aceste salarii ar putea să scadă începând de la 1 ianuarie 2019
Noul an vine cu vești proaste pentru unii dintre români, întrucât este posibil ca salariile lor să scadă, având în vedere faptul că în luna decembrie expiră o schemă de compensare ce a fost introdusă în februarie.
Marti, 02.10.2018, 10:13
Sute de mii de angajați s-ar putea trezi cu salariile scăzute, în următoarea perioadă! Ce se va întâmpla dacă Guvernul nu va acoperi pierderile
Angajaţii din IT, cercetare şi dezvoltare trec, pentru a doua oară în acelaşi an, prin teama scăderii salariilor. Acum, Guvernul este cel care suportă o parte din contribuţiile la sănătate tocmai pentru ca în urma trecerii contribuţiilor de la angajator la angajat salariile din aceste sectoare să nu scadă.
Luni, 01.10.2018, 19:54
Pas important în lupta împotriva poluării! Cercetătorii chinezi au inventat plasticul ce se dizolvă în apa sărată!
O echipă de oameni de ştiinţă din China a dezvoltat un tip de plastic ce se degradează în apă sărată şi ar putea contribui la diminuarea tendinţei din ce în ce mai îngrijorătoare a poluării oceanelor, relatează miercuri Xinhua.
Joi, 06.09.2018, 17:17
Un parc tematic din Franța a angajat pentru curățenie o echipă de... ciori!
Ciorile, adeseori lăudate pentru inteligența ridicată, au fost „dresate” pentru a aduna gunoiul într-un parc tematic din Franța!
Marti, 14.08.2018, 10:02
De ce se îmbolnăvesc copiii de leucemie. Un cercetător a aflat motivul cumplitei boli. Ce greșeală fac toți părinții și cum își pot feri copiii
De ce se îmbolnăvesc copiii de leucemie? – a fost întrebarea care l-a măcinat, timp de 30 de ani, pe un profesor de la „Institute of Cancer Research”, din Marea Britanie. Bărbatul a făcut publice mai multe concluzii pentru a-i avertyiza pe părinţi.
Marti, 29.05.2018, 13:36
Semnal de ALARMĂ! Apa îmbuteliată, contaminată cu particule de plastic
Cel mai recent studiu realizat de cei de la Universitatea de Stat din New York arată că 93% dintre sticlele cu apă îmbuteliată sunt contaminate cu particule de plastic.
Luni, 19.03.2018, 13:20
Cercetătorii au analizat în laborator sticlele de apă refolosite de către oameni. Rezultatul? Te va face să te gândeşti de două ori înainte să repeţi acest obicei!
O fiinţă umană poate trăi până la şapte zile fără apă. Însă, cu un corp compus în proporţie de 60% din apă şi având în vedere faptul că în jur de patru litri de apă sunt eliminaţi, zilnic, hidratarea este un element esenţial pentru o viaţă sănătoasă,aşa noi, în încercarea de a bea cantitatea de apă recomandată pentru consumul zilnic, facem tot ce putem, incluzând aici folosirea sticlelor de apă.
Luni, 17.07.2017, 10:50
Vrei să scapi de kilogramele în plus! Renunță la dietele care te fac să mori de foame: S-a aflat care este cel mai sănătos tip de regim alimentar
Oricât de tentante ar fi dietele restrictive pentru a scăpa de kilogramele în plus sau pentru atingerea unor scopuri în materie de performanțe sportive, acestea pot avea un efect negativ asupra sănătății inimii.
Joi, 30.03.2017, 14:58
La 50 de zile de la incendiul din clubul Bamboo, cercetarea la faţa locului se apropie de final
În timp ce anchetatorii se retrag pentru a analiza probele, administratorii lucreaza contracronometru. În câteva săptămâni, la mai puţin de 100 de metri distanţă de locul incendiului, se va deschide un alt club, al aceloraşi patroni,...
Marti, 14.03.2017, 19:44
Dezvăluirea care schimbă tot! Cercetătorii au recunoscut: "Există civilizaţii extraterestre!"
O întrebare pe care fiecare dintre noi, pământenii, și-a pus-o cel puțin o dată în viață este dacă suntem singuri în univers sau dacă extratereştrii există ori au existat vreodată. Până în prezent nu s-a dat un răspuns definitiv, fiecare putându-și imagina orice, relatează huffingtonpost.fr
Miercuri, 04.05.2016, 08:27
Ea ar putea fi PRIMA persoană din lume care NU va mai îmbătrâni: ”Vom scrie istorie”
Elizabeth Parrish, este director general al Bioviva USA Inc, susţine că este prima persoană din lume care nu va fi afectată de efectele îmbătrânirii naturale.
Marti, 26.04.2016, 09:11
Viviana Grădinaru, cercetătoarea din România care va fi premiată de președintele SUA!
Românca Viviana Grădinaru, cercetător principal la California Institute for Technology, se numără printre cei 105 câștigători din acest an ai ''Presidential Early Career Awards for Scientists and Engineers'', cea mai înaltă distincție acordată de conducerea SUA tinerilor specialiști în domeniul cercetării științifice și tehnologice
Marti, 23.02.2016, 22:35
Ai BARBĂ? Nu te rade! Cercetătorii britanici au făcut o descoperire de senzație!
Moda bărbilor lungi a câştigat teren şi în România! Nu mai e nimic ieşit din comun să vezi domni mândri de podoabele lor capilare, pe care nu ştiu cum să şi le îngrijească mai bine.
Joi, 04.02.2016, 23:12
Special! Barba distruge microbii
Cercetătorii britanici au luat bărbile la analizat şi au făcut o descoperire de senzaţie. În bărbile stufoase există bacterii care distrug anumiţi microbi. De acord, informaţia-bombă poate părea dezgustătoare. Dar să nu uităm că şi...
Joi, 04.02.2016, 20:14
O româncă din elita astronomiei dezvăluie adevărul: „Există viață extraterestră!”
Recent, o echipă de astronomi condusă de o tânără româncă a confirmat existenţa unei exoplanete similare cu Terra.
Marti, 05.01.2016, 14:41
A fost descoperit medicamentul care tratează... tot!
Mizând pe anihilarea sursei chimice care transmite semnalul durerii prin celulele din sistemul nervos către creier, oamenii de știință au încercat, fără succes, să elimine durerea fizică. Aparent, cercetătorii nu se uitau unde trebuie
Marti, 15.12.2015, 13:44
Creierul feminin și cel masculin nu sunt atât de diferite!
Zicala potrivit căreia bărbații vin de pe Marte și femeile de pe Venus e un clișeu, iar un nou studiu pare să o confirme
Miercuri, 02.12.2015, 14:33
Oamenii de ştiinţă sunt uluiţi! Află ce se întâmplă cu organismul tău atunci când mănânci brânză
Dependența de brânză poate fi comparată cu cea de droguri, tutun sau alcool, se arată într-un studiu realizat de mai mulţi cercetători de la Universitatea Michigan (Statele Unite).
Luni, 26.10.2015, 08:32